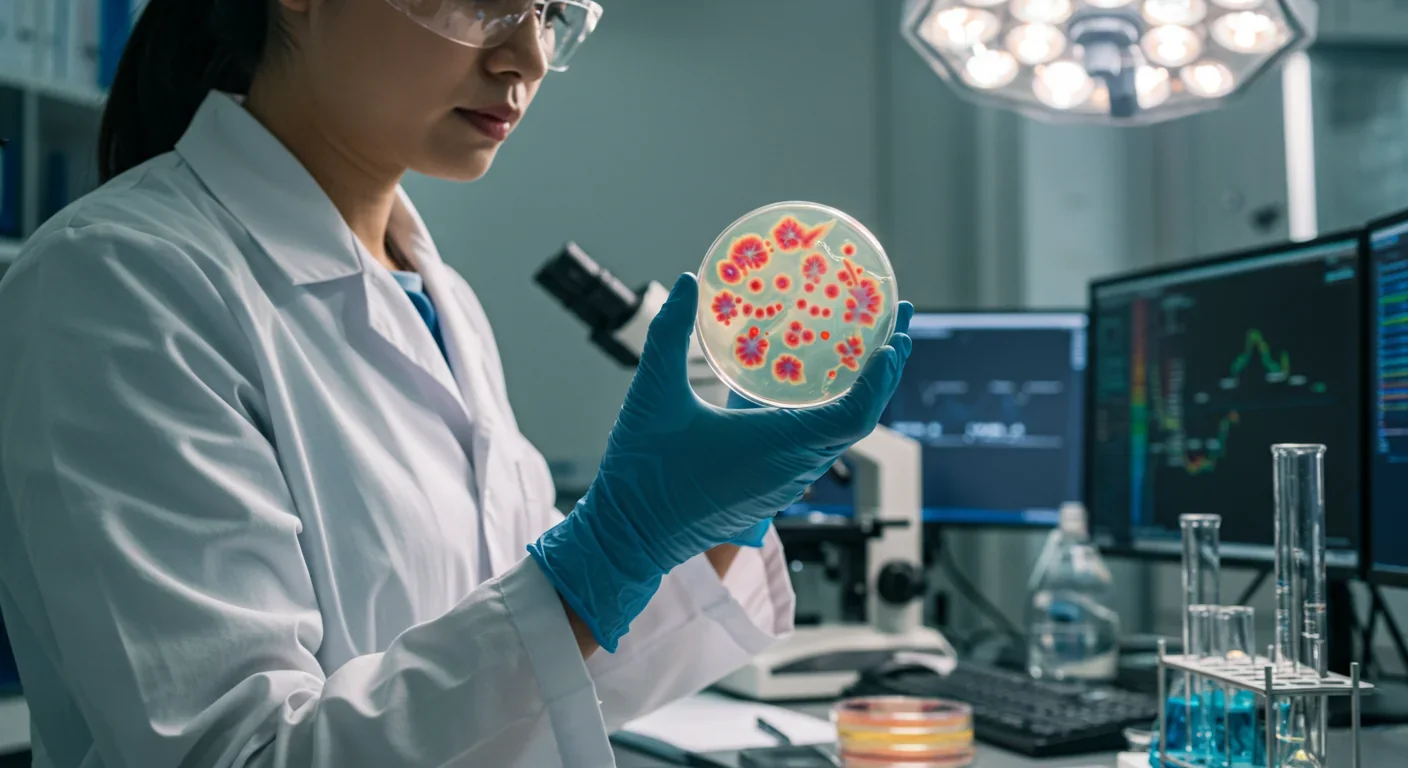

Epigenetic Clocks Predict Disease 30 Years Early

TL;DR: Scientists have identified keystone bacteria—just 3.6% of gut species that control ecosystem stability—and are engineering them into living medicines using CRISPR and synthetic biology. These engineered microbes show 85-95% success rates treating conditions from IBD to metabolic disorders, with the market projected to reach $3.2 billion by 2034. While offering transformative potential for personalized medicine and disease prevention, challenges include horizontal gene transfer risks, regulatory uncertainty, and ethical questions about enhancing human capabilities through bacterial programming.
By 2030, scientists predict that engineered gut bacteria will revolutionize how we treat everything from inflammatory bowel disease to depression. In an extraordinary leap forward, researchers have cracked the code on identifying and manipulating "keystone species"—the bacterial linchpins that hold our gut ecosystem together. These microscopic architects, comprising just 3.6% of gut bacteria species, wield disproportionate influence over the entire microbial community. Now, cutting-edge genetic tools are transforming them into living medicines that could replace conventional drugs for millions of patients worldwide.
The human gut harbors approximately 100 trillion bacteria, but not all microbes are created equal. Recent breakthroughs using artificial intelligence and network analysis have revealed that only 8.8% of prevalent genera and 3.6% of prevalent species qualify as keystones—the critical nodes that maintain ecosystem stability. Among these elite few, Faecalibacterium prausnitzii and Akkermansia muciniphila have emerged as the superstars of gut health engineering.
F. prausnitzii, which comprises up to 15% of the adult gut microbiome in healthy individuals, produces butyrate—a short-chain fatty acid that acts like a molecular Swiss Army knife. This metabolite provides energy for colon cells, strengthens the intestinal barrier, reduces inflammation by inhibiting NF-kB signaling, and even crosses into the brain to modulate iron metabolism and potentially protect against neurodegeneration. When levels drop, the consequences cascade: Crohn's disease risk increases, metabolic dysfunction emerges, and the entire gut ecosystem begins to unravel.
The discovery of these keystone species' outsized influence has transformed our understanding of gut health from a numbers game to a strategic chess match. Rather than flooding the gut with billions of random probiotics, scientists can now precisely target the bacterial generals that command the microbial army.
The journey from viewing bacteria as enemies to engineering them as allies represents one of medicine's most profound paradigm shifts. Just as the printing press democratized knowledge in the 15th century, our ability to read and write bacterial genomes is democratizing biological engineering in the 21st.
In 1676, Antonie van Leeuwenhoek first observed "animalcules" in human feces, but it would take three centuries before scientists recognized these microbes as partners rather than parasites. The antibiotic revolution of the 1940s initially reinforced the "bacteria as enemy" narrative. Broad-spectrum antibiotics became our nuclear option—effective against pathogens but devastating to beneficial microbes. Studies now show that a single course of antibiotics can reduce microbial diversity for up to six months, with some beneficial species never recovering.
The Human Microbiome Project, launched in 2007, marked our first systematic attempt to map this internal ecosystem. Like early cartographers charting unknown continents, researchers discovered that the gut microbiome contains 100 times more genes than the human genome itself. This genetic goldmine revealed why some people stay healthy while others develop chronic diseases despite similar lifestyles.
The keystone species concept, borrowed from ecology in the 1960s, finally gave researchers a framework for understanding gut dynamics. Just as removing wolves from Yellowstone caused ecosystem collapse, losing keystone bacteria triggers a cascade of dysfunction. This ecological lens transformed how we approach gut health: instead of carpet-bombing with antibiotics or randomly adding probiotics, we could strategically support the species that matter most.
Today's CRISPR-enabled precision mirrors the transition from bloodletting to targeted surgery. We're moving from the microbial equivalent of medieval medicine to molecular precision—a shift that will define healthcare for the next century.
Modern bacterial engineering employs a sophisticated toolkit that would seem like magic to scientists just a decade ago. CRISPR-Cas9 acts as molecular scissors, allowing researchers to insert, delete, or modify genes with base-pair precision. But the real breakthrough isn't just in cutting DNA—it's in understanding which edits will enhance keystone functions without disrupting the delicate ecological balance.
Consider bacterial surface display technology, where scientists program bacteria to express therapeutic proteins on their outer membranes. By displaying specific molecules, engineered F. prausnitzii can bind to inflamed intestinal tissues like a living bandage, delivering anti-inflammatory compounds exactly where needed. One recent innovation involves engineering these bacteria to produce a novel 12-kDa bacteriocin that selectively targets pathogenic species while sparing beneficial microbes—essentially creating a smart antibiotic that knows friend from foe.

The engineering process faces unique challenges. F. prausnitzii is notoriously difficult to culture, requiring strict anaerobic conditions and specialized growth media. Scientists have developed workarounds using cell-free supernatants—the metabolic "juice" that bacteria produce—which can deliver therapeutic benefits without the live organism. Studies show these postbiotic preparations match or even exceed live bacteria in protecting against liver fibrosis, reducing inflammation markers by 35%.
Perhaps most ingeniously, researchers are engineering synthetic cross-feeding networks. Since F. prausnitzii depends on other species like Bacteroides thetaiotaomicron to create favorable conditions, scientists design multi-species consortia that support each other. These bacterial teams work like a pit crew, each member performing specialized functions that benefit the whole community. MRM Health's CORAL platform exemplifies this approach, rationally combining disease-specific bacteria that outperform single-strain probiotics.
The therapeutic potential of engineered keystone bacteria extends far beyond traditional probiotics. In inflammatory bowel disease, where conventional treatments often fail or cause severe side effects, engineered consortia are showing remarkable promise. MRM Health's MH002, currently in Phase 2b trials, represents the most advanced rationally-designed bacterial therapeutic for ulcerative colitis, with early data showing both safety and efficacy.
For metabolic disorders, the evidence is equally compelling. Keystone bacteria modulate appetite through GLP-1 hormone production—the same pathway targeted by blockbuster weight-loss drugs like Ozempic, but through natural microbial signaling rather than pharmaceutical intervention. Clinical trials demonstrate that butyrate supplementation for just eight weeks significantly reduces weight, BMI, blood sugar, and LDL cholesterol in obese patients.
The economic implications are staggering. The global microbiome therapeutics market, valued at $212 million in 2024, is projected to reach $3.2 billion by 2034—a 31% annual growth rate driven by regulatory approvals and precision medicine adoption. Seres Therapeutics' VOWST, the first FDA-approved oral microbiome therapeutic for C. difficile infections, achieved 85-95% cure rates compared to 25% for standard antibiotics.
Beyond direct health benefits, engineered keystones offer systemic advantages. They're self-replicating, reducing the need for repeated dosing. They respond to environmental cues, ramping up therapeutic production during inflammation and scaling back when not needed. They can be designed with built-in safety switches, dying off if they escape the gut or encounter specific signals. This living pharmacy approach could transform chronic disease management from daily pills to occasional microbial tune-ups.
Cancer immunotherapy represents an unexpected frontier. Studies show that gut microbiome composition significantly influences checkpoint inhibitor response rates. By engineering keystone species to enhance immune activation, researchers could unlock immunotherapy benefits for the 60-70% of patients who currently don't respond.
Imagine walking into a clinic in 2035 and receiving a personalized microbial prescription based on your gut ecosystem analysis. This isn't science fiction—it's the logical extension of current developments. The shift from treating symptoms to engineering ecosystems will fundamentally alter how we conceptualize health and disease.
The societal implications ripple outward like stones thrown in a pond. In education, medical schools are already restructuring curricula to include microbiome ecology and synthetic biology. The next generation of doctors will think less like mechanics fixing broken parts and more like ecosystem managers maintaining balance. This ecological mindset could influence fields far beyond medicine—from agriculture to urban planning.
Workplace wellness programs will evolve from gym memberships to gut optimization services. Companies are beginning to recognize that employee productivity correlates with microbiome health. Google and Microsoft are already piloting programs that offer microbiome testing and personalized probiotic interventions. As one Silicon Valley executive noted, "We optimize our code; why not optimize our gut?"
The democratization of bacterial engineering tools raises profound questions about biohacking and enhancement. If keystone bacteria can improve mood, cognition, and energy levels, will "designer microbiomes" become the new performance enhancers? The same technology that treats disease could create unfair advantages in education, sports, and careers.
Cultural attitudes toward bacteria are already shifting. The COVID-19 pandemic's emphasis on sanitization is giving way to a more nuanced understanding of microbial partnerships. Parents increasingly seek "dirty" experiences for their children—farm visits, pet exposure, fermented foods—to build robust microbiomes. This cultural transformation from germophobia to "germophilia" represents a fundamental shift in how humans relate to the microbial world.
The path to microbial medicines isn't without peril. Horizontal gene transfer—bacteria's ability to share genetic material like trading cards—poses the greatest long-term risk. Engineered genes designed for therapeutic benefit could theoretically jump to native gut bacteria or even pathogens, with unpredictable consequences. While transformation, transduction, and conjugation occur naturally, adding engineered traits to this genetic marketplace requires extreme caution.
Antibiotic resistance genes (ARGs) present an immediate concern. Studies reveal that even beneficial probiotics can harbor ARGs, potentially creating reservoirs for resistance that could transfer to pathogenic species. After antibiotic treatment, ARG abundance can remain elevated for six months, turning the gut into a genetic library of resistance mechanisms. Any engineered therapeutic must be scrutinized for resistance genes that could undermine global antibiotic effectiveness.
Regulatory frameworks struggle to keep pace with innovation. The FDA's 2016 guidance on Live Biotherapeutic Products and the European Pharmacopoeia's 2019 definitions provide structure, but many questions remain. How do we assess safety for self-replicating therapeutics? What happens if engineered bacteria evolve after deployment? The EPA, FDA, and USDA recently released a joint web tool to help navigate this regulatory maze, but companies still face years of uncertainty and millions in compliance costs.
Ethical dilemmas multiply as capabilities expand. If we can engineer bacteria to influence mood and behavior through the gut-brain axis, where does therapy end and enhancement begin? The discovery that F. prausnitzii metabolites can cross into the brain and modulate iron metabolism raises questions about unintended neurological effects. Could we accidentally engineer personality changes while treating gut disorders?
Perhaps most concerning is the potential for irreversible ecosystem damage. Antibiotics taught us that disrupting the microbiome can have lasting consequences—some children who receive antibiotics before age three never fully recover their microbial diversity, facing increased risks of obesity, allergies, and autoimmune diseases throughout life. If engineered bacteria establish permanent residence and later prove problematic, removal might be impossible without destroying the entire ecosystem.
The race to commercialize engineered microbiomes reflects broader geopolitical dynamics. While American companies like Seres Therapeutics lead in regulatory approvals, European firms such as Belgium's MRM Health excel at rational consortium design. Asian researchers, particularly in Japan and South Korea, are pioneering postbiotic approaches that sidestep some regulatory hurdles by using bacterial metabolites rather than live organisms.
Cultural attitudes profoundly influence adoption patterns. Scandinavian countries, with their tradition of fermented foods and preventive healthcare, embrace microbial therapeutics enthusiastically. The Swedish government funds microbiome optimization programs in schools, viewing gut health as essential infrastructure for learning. Meanwhile, American insurance companies remain skeptical, rarely covering microbiome interventions despite mounting evidence of cost-effectiveness.
The global disparity in microbiome composition adds complexity. Research shows that bacterial communities vary dramatically by geography, diet, and lifestyle. Keystone species in Western populations might be marginal players in African or Asian guts. This diversity challenges the one-size-fits-all pharmaceutical model and demands locally adapted solutions. Companies are establishing "microbiome biobanks" in different regions to capture this diversity, raising questions about biological sovereignty and benefit-sharing.
China's approach offers a fascinating contrast. Rather than following Western regulatory pathways, Chinese researchers are integrating engineered bacteria with traditional medicine concepts. They're developing keystones that produce compounds from traditional Chinese medicine, creating hybrid therapeutics that resonate culturally while leveraging modern biotechnology. This synthesis could offer alternative development models for other nations seeking culturally aligned healthcare innovations.
International collaboration faces unique challenges. Shipping engineered bacteria across borders triggers biosecurity concerns. The Nagoya Protocol on genetic resources complicates sharing bacterial strains from different countries. Yet the need for cooperation is urgent—antibiotic resistance and chronic diseases don't respect borders, and neither should solutions.
The microbial revolution demands new skills and mindsets. Today's students should prioritize systems biology, learning to think in networks rather than linear cause-and-effect. Understanding ecology—not just human biology—becomes essential for healthcare professionals. Medical schools are beginning to require microbiome literacy, but the pace of change outstrips curriculum updates.
Programming skills will become as important as traditional wet-lab techniques. The ability to analyze metagenomic data, model bacterial interactions, and design synthetic gene circuits will define the next generation of bioengineers. Online platforms like Coursera and edX now offer specialized microbiome courses, democratizing access to this emerging field.
For professionals, the transition requires unlearning as much as learning. Doctors trained to prescribe antibiotics must now think twice about disrupting the microbiome. Nutritionists must consider not just what humans eat, but what their bacteria consume. Even psychiatrists are recognizing that mental health treatment might start in the gut rather than the brain.
Investors and entrepreneurs should watch for convergence opportunities. The intersection of AI and microbiome research promises breakthrough discoveries—machine learning models that predict keystone species, design optimal consortia, and personalize interventions. Companies that bridge traditional boundaries—combining fermentation expertise with genetic engineering, or merging diagnostic capabilities with therapeutic development—will likely dominate.
On a personal level, individuals can start preparing by building microbiome awareness. Keep a symptom diary correlated with diet and lifestyle. Get periodic microbiome testing to establish baselines. Experiment with fermented foods and prebiotics. Most importantly, resist the urge to over-sanitize—exposure to diverse microbes in childhood and throughout life builds resilience.
The revolution in engineered keystone bacteria represents humanity's next evolutionary leap—not through changing our own genes, but by optimizing our microbial partners. Within the decade, engineered bacteria will likely prevent more diseases than they treat, shifting healthcare from reactive to proactive. The question isn't whether this transformation will happen, but whether we're prepared to navigate its profound implications for human health, society, and what it means to be human in an age where our bacterial partners are programmable. The merger of human and microbial intelligence has begun, and the future of our species may depend more on the bacteria we engineer than the technologies we build.

Recent breakthroughs in fusion technology—including 351,000-gauss magnetic fields, AI-driven plasma diagnostics, and net energy gain at the National Ignition Facility—are transforming fusion propulsion from science fiction to engineering frontier. Scientists now have a realistic pathway to accelerate spacecraft to 10% of light speed, enabling a 43-year journey to Alpha Centauri. While challenges remain in miniaturization, neutron management, and sustained operation, the physics barriers have ...

Epigenetic clocks measure DNA methylation patterns to calculate biological age, which predicts disease risk up to 30 years before symptoms appear. Landmark studies show that accelerated epigenetic aging forecasts cardiovascular disease, diabetes, and neurodegeneration with remarkable accuracy. Lifestyle interventions—Mediterranean diet, structured exercise, quality sleep, stress management—can measurably reverse biological aging, reducing epigenetic age by 1-2 years within months. Commercial ...

Data centers consumed 415 terawatt-hours of electricity in 2024 and will nearly double that by 2030, driven by AI's insatiable energy appetite. Despite tech giants' renewable pledges, actual emissions are up to 662% higher than reported due to accounting loopholes. A digital pollution tax—similar to Europe's carbon border tariff—could finally force the industry to invest in efficiency technologies like liquid cooling, waste heat recovery, and time-matched renewable power, transforming volunta...

Humans are hardwired to see invisible agents—gods, ghosts, conspiracies—thanks to the Hyperactive Agency Detection Device (HADD), an evolutionary survival mechanism that favored false alarms over fatal misses. This cognitive bias, rooted in brain regions like the temporoparietal junction and medial prefrontal cortex, generates religious beliefs, animistic worldviews, and conspiracy theories across all cultures. Understanding HADD doesn't eliminate belief, but it helps us recognize when our pa...

The bombardier beetle has perfected a chemical defense system that human engineers are still trying to replicate: a two-chamber micro-combustion engine that mixes hydroquinone and hydrogen peroxide to create explosive 100°C sprays at up to 500 pulses per second, aimed with 270-degree precision. This tiny insect's biochemical marvel is inspiring revolutionary technologies in aerospace propulsion, pharmaceutical delivery, and fire suppression. By 2030, beetle-inspired systems could position sat...

The U.S. faces a catastrophic care worker shortage driven by poverty-level wages, overwhelming burnout, and systemic undervaluation. With 99% of nursing homes hiring and 9.7 million openings projected by 2034, the crisis threatens patient safety, family stability, and economic productivity. Evidence-based solutions—wage reforms, streamlined training, technology integration, and policy enforcement—exist and work, but require sustained political will and cultural recognition that caregiving is ...

Every major AI model was trained on copyrighted text scraped without permission, triggering billion-dollar lawsuits and forcing a reckoning between innovation and creator rights. The future depends on finding balance between transformative AI development and fair compensation for the people whose work fuels it.